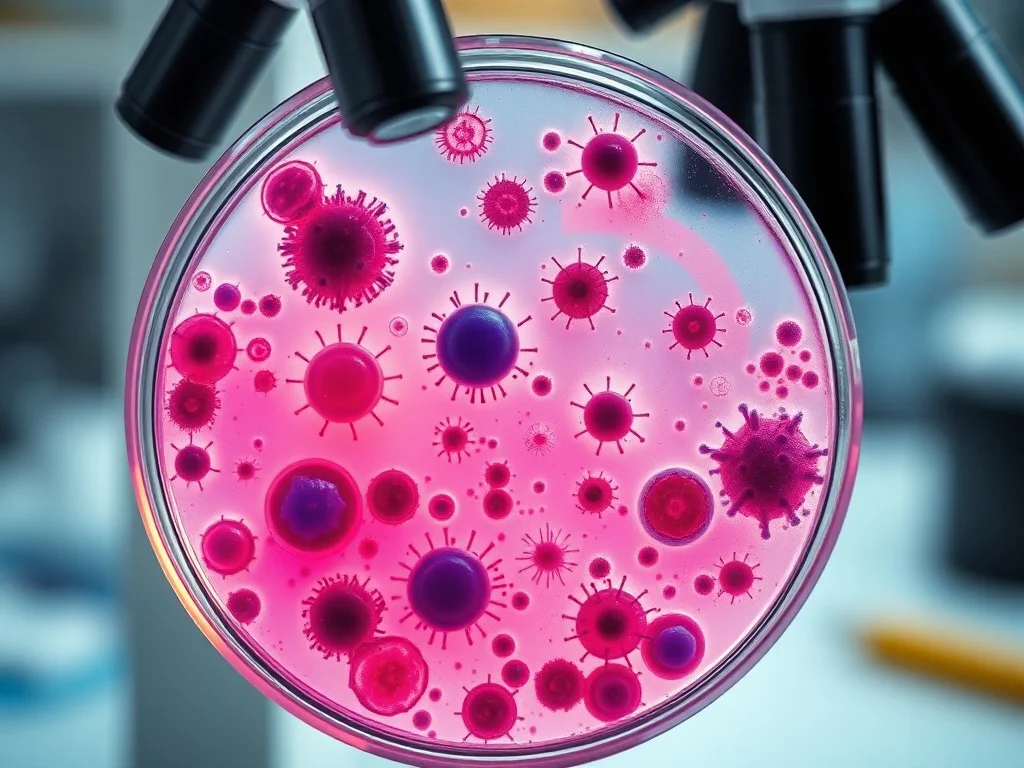
ATCC and Broad Institute Engineer New Cancer Models to Decode Resistance to Targeted Therapy

ATCC and Broad Institute Engineer New Cancer Models to Decode Resistance to Targeted Therapy
ATCC and the Broad Institute have collaborated to develop new cancer models that replicate clinically observed resistance mechanisms to targeted therapies. The models will be made available to support cancer research and potentially reveal new therapeutic targets.
ATCC and the Broad Institute have developed 13 isogenic non-small cell lung cancer cell lines using CRISPR gene editing to model resistance mechanisms to the EGFR inhibitor osimertinib. These models will be integrated into the Cancer Dependency Map to help build a response and resistance map of therapeutic vulnerabilities in cancer. The engineered models allow researchers to compare drug-sensitive and resistant cancer cells to uncover new therapeutic targets and drug combination strategies. The models and associated genomic datasets will be made available through ATCC and the DepMap portal. This collaboration addresses the challenge of treatment resistance in oncology, which inevitably develops over time despite initial clinical benefits from targeted therapies. By providing these cancer models, the researchers hope to reveal hidden targets and combination strategies to turn treatment failures into breakthroughs.
This content was automatically generated and/or translated by AI. It may contain inaccuracies. Please refer to the original sources for verification.